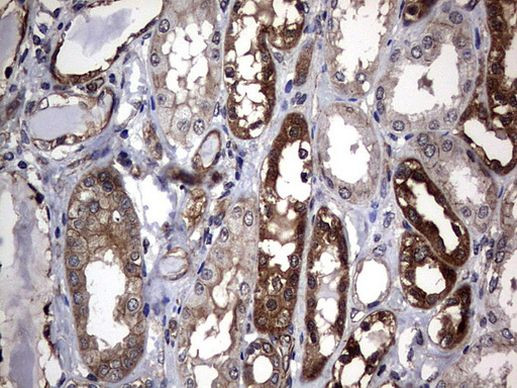
DDIT3 Antibody in Immunohistochemistry (Paraffin) (IHC (P))

Search
OriGene
DDIT3 Monoclonal Antibody (OTI2D3), TrueMAB™
{{$productOrderCtrl.translations['antibody.pdp.commerceCard.promotion.promotions']}}
{{$productOrderCtrl.translations['antibody.pdp.commerceCard.promotion.viewpromo']}}
{{$productOrderCtrl.translations['antibody.pdp.commerceCard.promotion.promocode']}}: {{promo.promoCode}} {{promo.promoTitle}} {{promo.promoDescription}}. {{$productOrderCtrl.translations['antibody.pdp.commerceCard.promotion.learnmore']}}
产品信息
TA802218
种属反应
宿主/亚型
分类
类型
克隆号
抗原
偶联物
形式
浓度
纯化类型
保存液
内含物
保存条件
运输条件
靶标信息
GADD153 is a small nuclear protein that is capable of dimerizing with transcription factors C/EBP alpha and beta. Once dimerized, this complex inhibits the normal binding and function of C/EBP to classical binding sites. Inversely, the C/EBP GADD153 dimer gains binding activity to other non classical C/EBP stress related targets. Under normal cellular conditions this protein is not expressed in detectable levels, but is highly unregulated during times of cellular/ER stress. Examples of GADD153 inducing stress include: treatment with tunicamycin, nutrient starvation and reducing agents that interfere with the calcium flux across the ER membrane.
仅用于科研。不用于诊断过程。未经明确授权不得转售。
篇参考文献 (0)
生物信息学
蛋白别名: C/EBP zeta; C/EBP-homologous protein; C/EBP-homologous protein 10; CCAAT/enhancer-binding protein homologous protein; CHOP; CHOP-10; DDIT-3; DNA damage-inducible transcript 3 protein; DNA-damage-inducible transcript 3; Growth arrest and DNA damage-inducible protein GADD153; MGC4154
基因别名: CEBPZ; CHOP; CHOP-10; CHOP10; DDIT3; GADD153
UniProt ID: (Human) P35638
Entrez Gene ID: (Human) 1649